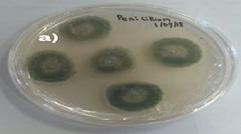
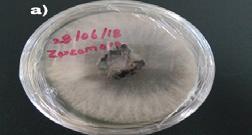

![]()



A cada expositor, a cada productor agrícola, ingeniero, proveedor y colaborador: gracias.
A mi super equipo incansable de Bajabrains, a los estudiantes de la UABC que sumaron talento y energía, y sobre todo… a mi familia, que es mi raíz y mi motor.
Y por supuesto, gracias a Dios, quien ha guiado cada paso hacia esta 4ta edición de la Expo AgroSQ.
Hoy cerramos una etapa con el corazón lleno de gratitud.
Y desde ya, abrimos la mirada al 2026… un año que será el inicio de algo mayor: una edición construida con visión, colaboración y sinergia.
3. Cosas que no sabias
5. Agro Turismo
7. Responsabilidad Social
9. Fotos Expo AgroSQ
11. “Una historia de amor por San Quintín”. Relato de vida de Don Ramón Magaña
13. Fotos Expo AgroSQ
15. Master del Campo
17. Podredumbres blandas en Berries en el Valle de San Quintín
19. Fotos Expo AgroSQ
21. Mamá Espinoza y el sabor que abrió camino
23. Directorio


Madlam Grupo (616) 101 5334
¿Sabías que…? Madlam Grupo no solo ofrece servicios de recolección de basura y renta de contenedores: es una empresa local que ha elevado el estándar en limpieza y gestión de residuos en la región. Desde la imagen impecable de sus contenedores hasta la operación eficiente de sus dos camiones recolectores dedicados, Madlam refleja calidad en cada detalle. Y algo que muchos reconocen: el profesionalismo y la atención al cliente que ofrece su propietario, junto con todo su equipo de trabajo, han hecho de esta empresa un aliado confiable en eventos, empresas y comunidades que apuestan por un entorno limpio y ordenado.


108 6647
¿Sabías que…? Si estás buscando desde materiales de construcción hasta equipo eléctrico, lo podrás encontrar en Petsa Express. Su amplio inventario y diversidad de productos los ha convertido en un punto de referencia para contratistas, agricultores y empresas locales que necesitan soluciones rápidas, confiables y todo en un solo lugar. En eventos como la Expo Agro San Quintín, su presencia reafirma el papel clave que tienen las ferreterías integrales en el desarrollo de la infraestructura agrícola regional.
¿Sabías que…? Mercado Arenas es más que un mercado: como empresa local, ha crecido hasta contar con seis sucursales estratégicamente ubicadas en colonias clave como La Cali, El Papalote, Fracc. San Quintín, Vicente Guerrero y Díaz Ordaz —además de incluir el Mercado Stoker y el Mercado Uruapan— convirtiéndose en una de las cadenas más influyentes en la distribución de abarrotes, productos frescos y artículos de uso diario en la región de San Quintín. Su alcance comunitario refleja una tendencia clave: el fortalecimiento de redes comerciales locales como motor de desarrollo agrícola y social.


268 4993
¿Sabías que…? Eventos Amy (también conocida como Amy Decoraciones) ofrece decoraciones temáticas personalizadas, incluidas rosas eternas, peluches y arreglos minimalistas desde precios accesibles, alineándose con tendencias de eventos agrocorporativos personalizados en la región.
226 2885
¿Sabías que…? Diken, fundada en 1989, es una empresa de clase mundial en higiene, limpieza profesional y seguridad industrial, y participa activamente en seminarios de inocuidad alimentaria en ferias como Expo Agro, reflejando su compromiso con la calidad en el sector agroalimentario


¿Sabías que…? Homebox Living ofrece soluciones modulares eficientes y adaptables para transformar tanto espacios habitacionales como áreas de trabajo en eventos agroindustriales, una tendencia que está al alza en arquitectura temporal sostenible.


Desde que tengo memoria, mi vida ha estado ligada al campo. Aunque nací en Ensenada, me crié en San Quintín, y aquí sigo. Esta tierra me eligió y yo la elegí también. Como decía mi abuelo: “La tierra se trabaja, se respeta y se agradece”, y eso lo aprendí no con discursos, sino con el ejemplo.
Cuando terminé la prepa no sabía qué estudiar, pero pensé: “Si aquí crecí y aquí
me siento pleno, entonces me voy por agronomía”. No me equivoqué. Con los años, una sobrina y yo empezamos a imaginar lo que hoy es San Quintín Sensorial: una experiencia que va más allá del cultivo. “Queremos que la gente entienda el esfuerzo que hay detrás de una simple cajita de fresas”.
Aquí no solo sembramos frutas, sembramos vivencias. Recibimos visitantes de Ensenada, Tijuana, San Diego… Gente que viene a conocer, probar, sentir. A veces les digo: “La fresa no nace en el supermercado. Detrás hay jornadas largas, tecnología y personas reales”
Hemos modernizado empaques, explorado drones para fumigar, y colaboramos con viñedos para ofrecer maridajes gastronómicos. Pero también enfrentamos retos. “Nuestra agua dulce es más salada que el mar”, y eso nos obliga a innovar.
San Quintín tiene todo para convertirse en un referente. Yo sueño con que, cuando alguien pruebe una de nuestras fresas, sepa que ahí va también nuestra





El domingo 15 de junio, se llevó a cabo en Tijuana el primer medio maratón convocado por la Fundación castro Limón. Los participantes nos unimos con pasos llenos de amor y compromiso para apoyar a los pequeños en su lucha contra el cáncer.
Más de 2,500 corredores tuvimos un solo propósito: apoyar la vida de niñas y niños en tratamiento contra el cáncer.
Un equipo de 17 corredores de San Quintín ofrecieron sus pasos por esta causa, y otros 10 voluntarios mas atendieron los puntos de hidratación, como parte del programa de voluntariado Driscoll´s.
Cuando la comunidad se une suceden cosas poderosas, construimos nuevas oportunidades para el desarrollo local, desde las capacidades que tenemos como sociedad. Este músculo social necesitamos seguir ejercitándolo para que poco a poco continúe creciendo y fortaleciéndose. En sociología se le llama capital social.
Este músculo social lo compone toda la sociedad, empezando por la familia, los vecinos de la cuadra, la colonia, la comunidad, las escuelas, los pequeños negocios y las empresas así como las instituciones. Los voluntarios podemos ser cualquiera de nosotros, apoyando en favor de los temas que nuestra comunidad requiere.


Escuchar las necesidades de la comunidad en donde operamos y contribuir a que esta se desarrolle fuerte y productiva, debe ser una prioridad en las empresas. Sin duda, es necesaria la colaboración y esfuerzo de todos los sectores para continuar construyendo la comunidad que queremos y merecemos en el valle de San

Cada comunidad es un lugar único, donde vivimos y crecemos. Les invito a unirse en el fortalecimiento del músculo social.
René Moreno / Consejero del CABC













Nací en 1940, en la Colonia Guerrero, en una época en la que no había doctores ni hospitales. Como se acostumbraba entonces, nací en casa, con partera. Desde niño, mi vida estuvo ligada al campo. Mi padre llegó desde Zamora Michoacán con la firme intención de sembrar y formar una vida aquí, en San Quintín. Empezamos sembrando lo básico: maíz, frijol, trigo… luego vinieron los chiles, las papas, el tomate, el brócoli. La tierra nos fue marcando el rumbo.

“Todo lo construimos desde cero”. Mi padre y mis tíos llegaron en 1935 como jornaleros para trabajar en la carretera entre Ensenada y San Quintín. Llegaron con las manos vacías, pero gracias a su esfuerzo, pudieron comprar camiones y acceder a terrenos que el presidente Sánchez Taboada les ofreció. Renunciaron al ejido de Maneadero y comenzaron aquí, como pequeños propietarios. No había nada. Todo lo que ves hoy fue sembrado con trabajo.
“Lo que somos, lo somos por el trabajo, la tierra… y porque nunca nos rajamos”
Recuerdo que fuimos los primeros en tener una deshidratadora de chiles. Procesábamos todo tipo: pasilla, serrano, morrón… En aquel tiempo, donde hoy ves fresas, solo había chile.
Una de las experiencias más duras la viví cuando tenía 1 año y medio, cuando tomé gasolina por accidente. Mis padres tardaron 20 horas en llevarme a Ensenada por caminos de pura terracería. Me salvaron con penicilina, uno de los primeros casos en México. “Estuve entre la vida y la muerte”.
La agricultura nos dio mucho. Llegamos a entregar cuatro mil toneladas de papa a Sabritas en tres meses. “Las mejores papas de México salían de aquí”. Nadie en el país producía lo que nosotros. Pero también han venido tiempos difíciles. Hoy sobrevivimos gracias al agua de mar y las desaladoras. Los pozos ya no sirven.
San Quintín depende del campo. Aquí todo gira alrededor de la agricultura. También existen otras actividades como la pesca, la minería o la ganadería, pero la falta de lluvia ha complicado bastante las cosas.
No muchos lo saben, pero antes que nosotros estuvieron aquí los ingleses. Tenían tecnología avanzada, incluso un tren que iba desde el molino hasta donde hoy está la universidad UABC. Cuando se fueron, intentaron llevarse la locomotora, pero se volcó el barco. Ahí quedó y aún sigue ahí, en el fondo de la bahía.
No fui a la escuela. Desde niño me tocó entrarle al trabajo: cocinaba para los trabajadores, ordeñaba vacas, hacía queso, sembraba. Desde chico ya manejaba solo desde el rancho hasta la Colonia Guerrero. La responsabilidad llegó desde temprano.
Y sí, comí mucha víbora de cascabel. En caldo, asada, frita… como fuera. “Era lo que había”. Luego descubrimos que es buena para la salud. Después de un accidente en el que me destrocé la pierna, me injertaron piel. El médico esperaba un 30% de éxito, pero el 95% prendió. Me dijo: “Tiene una de las san-


gres más puras que he analizado”. Yo se lo atribuyo a la cascabel.
Hoy tengo 81 años y sigo aquí, donde
nací. He visto crecer este valle desde tierra virgen. “Lo que somos, lo somos por el trabajo, la tierra… y porque nunca nos rajamos”.










Nombre: Ing. Eleno Gálvez Camargo
Carrera: Ing. AgronomoParasitologo
Años de Experiencia: 39 años
Empresa para la que labora: Quimica Sagal
Años en el cargo: 15 años
¿Cuáles han sido los principales desafíos que ha enfrentado en la gestión de la salinidad del suelo en el Valle de San Quintín, y cómo los ha abordado en sus proyectos?
El principal problema es el continuo aumento en la salinidad de los suelos, esto derivado a factores diversos, como lo es principalmente el mono-cultivo en los suelos, dado que el valle de San Quintín es hortícola, esto ha aumentado con la instalación de mallas sombras y/o invernaderos, porque estas se destinan a tomates y/o pepinos principalmente, tocando cada vez que se planta el cultivo en la misma zona, los fertilizantes, el agua con C.E. (conductividad eléctrica) en aumento a ayudado mucho en su incremento. Para abordar este problema es necesario saber cómo esta nuestro suelo con qué porcentaje de sales y determinar una estrategia para tratar de minimizar o corregir el problema.
¿Cómo ha aplicado sus conocimientos en parasitología agrícola para controlar y manejar plagas y enfermedades en culti vos del Valle de San Quintín, y qué resul tados ha obtenido?
En este sentido se tiene un parámetro de incidencia, tanto de insectos-plaga como de patógenos, cada plaga, en cada cultivo se trata distinto, por ejemplo el trips, plaga muy común aquí en el valle, se trata diferente para los cultivos de tomate (muy importante) por ser transmisor de virus, pepinos, como plaga succionadora de savia, cebollas como un huésped en cultivo, su control es químico, aun que hay otras estrategias.
¿Puede compartir algún proyecto específico en el que haya trabajado en el Valle de San Quintín, donde haya aplicado su experiencia en revisión de salinidad del suelo y parasitología agrícola, y qué impacto ha tenido en la productividad y sostenibilidad de los cultivos?
El proyecto para la salinidad empieza, con un análisis de laboratorio, esto nos arroja una información de lo que tenemos en nuestro suelo ds/m o ppm. de sales, convertida a partes por millón y es el indicador para realizar un programa de aplicaciones, mejoradores de suelo (Ac. Carboxílicos sustancia húmica, Ac. fúlvicos) yeso agricola, lavado de raíces entre otras medidas.
¿Cómo ha colaborado con otros expertos, como agricultores, investigadores y autoridades locales, para abordar los desafíos agrícolas en el Valle de San Quintín, y qué lecciones ha apren dido de estas co laboraciones?
En este sentido se toma muy en cuenta el estado de in fección de nuestro suelo, sean estos, hongos, bacterias y/o
nematodos, de los puntos más importantes, y sobre todo nos arroja un resultado el análisis de laboratorio, esto es el indicador principal, para tomar decisiones que nos ayuden a controlar o bajar las poblaciones UFC (unidades formadoras de colonia), esto es principalmente con ayuda de aplicaciones químicas al suelo.
¿Qué recomendaciones tendría para los agricultores y productores del Valle de San Quintín, basadas en su experiencia, para mejorar la sostenibilidad y productividad de sus cultivos en un entorno con restricciones de agua y suelo?
Las recomendaciones serian algunas que los agricultores y/o agrónomos de campo, ya las conocen la principal, aná lisis de pasta de nuestro suelo para saber que tenemos en nuestra zona de producción, tanto como en el aspecto patológico, como salini dad, análisis del agua de riego (C.E.), PH, para atacar esos problemas, sin estos factores la productividad de nuestro suelos se ve reducida.





La enfermedad conocida como podredumbre blanda, es una de las enfermedades poscosecha más comunes en frutas y hortalizas; dentro de las primeras podemos destacar a las berries, que incluyen a la zarzamora, frambuesa, arándano y fresa, cultivos de importancia en el valle de San Quintín por las grandes extensiones de tierra dedicadas a ellos y su valor económico. Estas enfermedades pueden ser causadas tanto por bacterias como por hongos, pudiendo diferenciarse fácilmente por la presencia de un olor desagradable en el caso de las bacterias y por un crecimiento micelial en el caso
Patógeno
de los hongos. Entre los principales hongos causantes de pudriciones blandas se encuentran Aspergillus niger, Mucor sp, Penicillium digitatum, Pythium sp, Rhizopus stolonifer y Botrytis sp, este último conocido como podredumbre gris tanto en campo como en poscosecha por el aspecto que se observa en las frutas dañadas. En la Facultad de Ingeniería y Negocios San Quintín se llevan a cabo técnicas de aislamiento, purificación e identificación de estos patógenos, principalmente basados en su morfología ma-croscópica y microscópica (figura 1). La identificación de los agentes causales adquiere rele-
Días de Aparición
Botrytis spp. 15 ± 1
Rhizopus spp.
18 ± 1
Penicillium spp
18± 1
Colletotrichum spp.
vancia para su prevención y manejo poscosecha. Dentro de las técnicas de manejo integrado de estas enfermedades se encuentran el uso de microorganismos antagonistas como Trichoderma sp y Bacillus sp en el campo y persiste también el uso de fungicidas y bactericidas. En la etapa de poscosecha es fundamental el control de temperatura y humedad relativa y adicionalmente, se investiga el uso de tecnologías que plantean el uso de sustancias GRAS (generalmente reconocidas como seguras, por sus siglas en inglés) aplicadas como recubrimientos comestibles, vapores, entre otros.
Días de Aparición Morfología microscópica

21± 1
Sclerotinia sp.
20 ± 1






Figura 1- Géneros de hongos aislados a partir de frutos de zarzamora en condiciones de almacenamiento a 0°C y 90 ± 5 % con sus días de aparición, cuya identificación morfológica se basa en (Agrios et al., 2011).

Laura Dennisse Carrazco Peña es Ingeniera Bioquímica en Alimentos (Instituto Tecnológico de Los Mochis), Maestra en Ciencias en Manejo Poscosecha (Centro de Investigación en Alimentación y Desarrollo, Unidad Culiacán) y Doctora en Ciencias Químicas (Universidad de Colima). Actualmente es Profesora Investigadora de FINSQ de la UABC y pertenece al SNII.

Salvador Ordaz Silva es originario del ejido La Victoria, municipio de San Pedro de las Colonias, Coahuila, egresado de la Universidad Autónoma Agraria Antonio Narro como Ingeniero Agrónomo Parasitólogo y Maestro en Ciencias y Doctor en Ciencias en Parasitología Agrícola. Es Profesor e investigador desde el 2014 y 2016, respectivamente, en la FINSQ de la UABC y pertenece al Sistema Nacional de Investigadoras e Investigadores (SNII) desde el 2016.
Ambos profesores forman parte del Cuerpo Académico Agrobiotecnología.











“BerryFest
La idea nació en el corazón del campo, entre surcos de fresas y jornadas de cosecha. Los organizadores del BerryFest San Quintín nos cuentan que no se trata solo de celebrar la fruta, sino de celebrar a la gente. “Queremos que cada trabajador agrícola, cada familia, cada persona que ha dado su vida al campo, se vea reflejada en este festival”, comparten con emoción.
San Quintín es una potencia mundial en la producción de berries: fresas, frambuesas, arándanos y zarzamoras que cruzan fronteras. Pero detrás de ese éxito está la identidad de una región entera, y eso es lo que BerryFest busca poner al centro.
“El festival será gratuito y para todos. Queremos que la comunidad se apropie de él, que lo sienta suyo”, explican. Entre las actividades planeadas, destacan un certamen de belleza muy especial: cada rancho productor podrá proponer a una representante para el concurso Reina de las Berries, pensado para homenajear a la mujer del campo con dignidad y alegría.
Pero BerryFest también será un festival de sabores. “La mejor fruta de la temporada se va a presentar en todas sus formas: postres, botanas, platos

principales, y maridajes con vinos y cervezas artesanales de la región”
La gastronomía será uno de los pilares, con una zona de degustación y un área para chefs invitados que trabajarán con productos locales.


La cultura también tendrá un lugar especial. Se esperan presentaciones musicales, muestras de arte agro, exposiciones fotográficas de la vida en el campo y talleres infantiles para que los más pequeños aprendan sobre el ciclo de cultivo.



“El objetivo final es fortalecer el orgullo agrícola. Queremos que los trabajadores del campo se sientan reconocidos. Que los productores vean su historia reflejada. Que las familias digan: ¡Esto es San Quintín!”, concluyen.
Con este primer BerryFest, San Quintín no solo exportará sabor… también identidad, belleza y comunidad.







Hablar de langosta en Baja California es hablar también de historia, carretera… y de Mamá Espinoza.
Mucho antes de que existieran los festivales, los foodies o las rutas gastronómicas, ya había una mujer cocinando con amor en El Rosario. Su nombre era Anita Grosso, aunque para todos —viajeros, aventureros, gringos y locales— fue simplemente Mamá. La señora que ayudaba a quien pasara, que hablaba inglés perfecto, que servía comida caliente y que siempre tenía una sonrisa lista.
La historia dice que fue maestra, costurera, vendedora y madre de diez hijos. Pero lo que muchos no saben es que también fue pionera del sabor. Cuando la carretera transpeninsular aún era un sueño de terracería y mapas dibujados a mano, ya llegaban a su casa los primeros turistas buscando gasolina, indicaciones… y algo que comer. Y ella, sin hacer ruido, fue dando forma a lo que hoy entendemos como cocina típica bajacaliforniana.
La langosta —fresca, local, cocinada con mantequilla, servida con frijoles, arroz y tortillas de harina— se convirtió en su carta de presentación. No como plato de lujo, sino como bienvenida. Como un abrazo en forma de platillo.
Con los años, la fama creció. Su casa se volvió parada obligada. Su nombre cruzó fronteras. Y la receta, ese sabor tan sencillo pero inolvidable, se convirtió en leyenda.
Hoy que nos preparamos para celebrar el Langosta Fest en San Quintín, queremos rendir homenaje a esa mujer que abrió la mesa para todos. Porque antes que chefs, hubo manos como las suyas. Antes que festivales, hubo mesas de cocina como la suya. Y antes que hablar de tradición, ya Mamá Espinoza estaba dejando huella con un sartén, un fogón y su hospitalidad.
Este festival es por la langosta, sí… pero también por ella. Porque cada mordida que damos tiene historia.

Grupo Logístico Rodríguez
Tel: +52 664 683 1022
Correo: hola@glrodriguez.mx
Fb: Grupo Logístico Rodríguez
Ig: glrodriguezmx
W: glrodriguez.mx
Hutchison Ports EIT
Tel: 646 178 8801
Correo: Cruz.omar@enseit.com
Fb: Hutchison Ports EIT
W: hutchisonportseit.com
Villanueva Lorenzo Agentes Aduanales
Tel: 686 278 3960
Correo: ivan@villanuevalorenzo.com
Fb: Villanueva Lorenzo Agentes Aduanales
Ig: villanuevalorenzo_aa
W: villanuevalorenzo.com
Agri Star México
Tel: 331 918 0485
Correo: contacto@agristar.com.mx
Fb: Agri Star México
Agroindustrias Químicas y Biológicas
Tel: (81) 8000-1877 / (667) 688-0847
Correo: contacto@aqb.com.mx
Fb: Agroindustrias Químicas y Biológicas Ig: @aqbmexico
Agroindustrias Unidas Del Centro, “Agrocent Baja California.”
Tel: 616 107 1097
Correo: srmachuca1974@gmail.com
Fb: Agrocent Baja California
Agrokorita
Tel: 311 237 7963
Correo: marketing@agrokorita.com
Fb: AgrokoritaMX
Agronegocios Balbo
Tel: 612 1680 651
Correo: agronegociosbalbo.bcs@gmail.com
Fb: agronegocios balbo
Ig: agronegocios balbo
Agroquímicos Peninsulares Camalú
Tel: 616 166 2880
Correo: informacion@peninsulares.com
Fb: Agroquímicos Peninsulares Camalú
Agrorgánicos Nacionales
Tel: 667 760 6256
Correo: cln@agrorganicosnacionales.com
Fb: Agrorgánicos Nacionales
Ig: @agrorganicosnacionales
Agroscience
Tel: 33 1114 1828 y 800 570 6766
Correo: contacto@agroscience.com
Agrovela
3310721464
Correo: lic.ladislao27@gmail.com
Fb: Agrovela
Ig: @agrovela W: agrovela.com.mx
Apelsa Guadalajara
Tel: 333 607 2430
Correo: j.guevara@apelsagdl.com.mx W: apelsagdl.com.mx
Baja Agro International
Tel: 646 177 0475
Correo: jromo@yucca.com.mx
Fb: baja agrointl Ig: bajaagrointl W: yucca.com.mx
Baja Plants
Tel: 616 166 8040
Correo: gerardocamilo@bajaplants.com.mx
Fb: Baja Plants W: bajaplants.com.mx
Biogold
Tel: 667 714 8886
Correo: info@biogold.com.mx
Fb: Biogold.oficial
Corteva Agriscience
Tel: 333 679 7979
Correo: adalberto.ramirez@corteva.com
Fb: Corteva Agriscience Ig: cortevamx W: corteva.mx
Hidropónica
Tel: 786 139 1901
Correo: Ventas@hidroponica.com.mx W: hidroponica.com.mx
Icassa
Tel: 616 135 2882 / 646 200 6152
Fb: ICASSA de C.V.
Intrakam
Tel: 844 1222 221
Correo: g_kamara@intrakam.com.mx
Fb: Intrakam W: intrakam.com
Koppert México
Tel: 442 221 6149
Correo: ventas@koppert.com.mx
Mar y Tierra Fertilizantes Orgánicos
Tel: 646 196 4338
Correo: mkt@marytierra.com.mx
Fb: Mar y Tierra Fertilizantes Orgánicos Ig: marytierraorganics
W: marytierra.com.mx
Organia de México y Remmy de México
Tel: 556 867 7682
Fb: organiademex
W: organiademexico.com
Plaguicidas Cucapah
Tel: 686 119 3817
Correo: pcucapah@hotmail.com
Plantlogic México
Tel: +52 1 33 1356 6192
Correo: sales@getplantlogic.com
Fb: plantlogic
PNM International
Tel: 443 213 4109
Correo: dir.administrativo@pnm.com.mx W: pnm.com.mx
Quimical
Tel: 616 166 2336
Fb: quimical.mx
Ig: quimical.mx
W: quimical.mx
Tecnologías AgriBest
Tel: 55 4833 2159
Correo: Infoventas@agribest.com.mx
Fb: AgriBest
Ig: AgriBest Mx W: agribestmx.com
Temisa
Tel: 333 956 6016
Correo: info@tecnicamineral.com.mx
Tessenderlo Kerley México
Tel: 646 193 1819
Correo: gabriela.juarez@tkinet.com
Fb: Tessenderlo Kerley Mexico W: tessenderlokerley.com
Yara México
Tel: 33 8526 2750
Correo: brenda.palacios@yara.com
Fb: Yara México
W: yara.com.mx
Biobest México
Tel: 333 283 4639
Correo: czatarain@imex.mx
Fb: biobestmx W: imex.mx
Multiservicios Apicolas
Tel: 477 700 0959
Correo: jonas_80_1@hotmail.com
Fb: Multiservicios Apicolas multi_api
Agencia Jeep, RAM, Peugeot, Fiat, Dodge Ensenada
Tel: 646 900 91 00
Correo: mpuga@autoproductos.com.
Fb: Jeep autoproductos
Ig: RAM auto productos
W: Peugeot auto productos
Baja X Sports
Tel: 664 607 2727
Correo: info@bajaxsports.com
Fb: bajaxsports Ig: bajaxsports W: bajaxsports.com
Chevrolet Ensenada / Motores de Tijuana
Tel: 646 176 0208
Correo: aclientes@gmtijuana.com
Fb: Chevrolet Ensenada
Ig: chevroletensenada
Honda Ensenada
Tel: 646 900 9000
Correo: clabro@hondaoptima.com
Fb: Honda Optima
Ig: hondaoptima
W: hondaoptima.com
Mitsubishi Tijuana
Tel: 664 969 1979
Correo: mpuga@autoproductos.com.
Fb: Mitsubishi Tijuana
Ig: Mitsubishi.autoproductos
Nissan Ensenada
Tel: 646 176 6118
Automotriz
Volkswagen Tijuana
Tel: 664 634 2444
W: vw-tijuana.com.mx
Bin Bodega Industrial
Tel: 667 175 4738
Correo: Ventas@bodega-industrial.com
W: bodega-industrial.com.mx
Flow industrial
Tel: 686 945 2840
Correo: Ventas@flowindustrial.com.mx
Fb: Flow industrial
Rio Industrial Supply and Services
Tel: 664 299 0440
Correo: rio.supplytj@gmail.com
Fb: riosupplytj
Ig: rio.hydraulics
W: oleohidraulicariotj.com
The Amp Company
Tel: 664 121 5962
Correo: marketing@ampco.mx
Fb: The amp company
Ig: The_ampcompany
Villarreal Bombas y Sistemas
Tel: 646 177 1450
Correo: Compras@villabombas.com
Fb: Villarrral Bombas Y Sistemas
International De Baja California
Tel: 646 120 8700
Correo: gtemkt@ibc.com.mx
Fb: International de Baja California Ig: international.ibc
W: ibc.com.mx
Kenworth DAF del Noroeste
Tel: 616 165 3121
Correo: jmgonzalez@kwn.com.mx
Fb: Kenworth DAF del Noroeste Ig: kenworthdafdelnoroeste W: kwn.com.mx
Velocity México
Tel: 686 555 2500
Correo: marketing@canorsa.com
Fb: Velocity Mexico
W: velocitymexico.com.mx
Baja Contenedores
Tel: 686 215 9434
Correo: contacto@bajacontenedores.com
Fb: bajacontenedores
Homebox Living
Tel: 6861573552 y 686 851 9772
Correo: Homeboxliving@gmail.com
Fb: Homebox living
J.JMiteri
Tel: 33 3632 6141 y 33 3694 5967
Correo: info@jjmiteri.com
Fb: JJMiteri
Ig: jjmiteri
W: jjmiteri.com
Franco Servicios
Tel: 646 2872930
Correo: daniela@francoservicioc.com W: francoservicios.com
CUARTOS FRIOS
Driscoll’s
Tel: 616 166 1200
Correo: contacto.mexico@driscolls.com
Fb: DRISCOLLS MÉXICO W: driscolls.com
DISTRIBUCIÓN DE HIDROCARBUROS
Circulo Llantero
Tel: 664 624 6075
Correo: czamora@circulollantero.com.mx W: circulollantero.com
Enercard Tel: 616 107 1135 / 616 165 2252
Correo: elepe@enercard.com.mx
Fb: EnercardMx Ig: @enercardoficial W: enercard.com.mx
Grupo Energéticos
Tel: 818 253 2709
Correo: ventas@grupoenergeticos.com
Fb: Grupo Energeticos
Lumaggs Tel: 664 563 4361
Correo: lumaggsbc
Fb: lumaggsbc
Ig: chevron@lumaggs.com.mx
EMPAQUE
Altera Tel: 644 411 0404
Correo: Compras@altera.com.mx
Fb: Altera industrial W: grupoaltera.com
Centrus Packaging Tel: 686 523 6747
Correo: mkt@centruspackaging.com
Fb: Centrus packaging
Ig: centrus_packaging W: centruspackaging.com
Compañía Arizlu Tel: 331 418 4328
Correo: ventas@arizlu.com / aaron.tello@arizlu.com
Empaques Internacionales
Tel: 646 294 4858
Correo: Oficina@intlpackaging.com
Fb: Empaques internacionales grupo govep
Moldex
Tel: 442 234 1230
Correo: rauld@moldex.com
linkedin: https://www.linkedin.com/company/ moldex-am-rica-latina
W: moldex.com
Paak
Tel: 616 113 8577
W: paak.mx
Smartco De México
Tel: 664 902 8613
Correo: info@smartco.mx
Fb: SmartCo Packaging Solutions
V-NOR
Tel: 663 203 4637
Correo: c.alatorre@v-nor.com
Fb: V-NOR
Ig: VNORTJ
Aceros Frontera
Tel: 664 409 9953
Correo: ventas@acerosfrontera.com
Fb: Aceros Frontera
Ig: aceros.frontera
W: acerosfrontera.com
Grupo EYP
Tel: 616 165 2015
Correo: Gerencia.sq@eyp74.com
Fb: Grupo EYP
W: grupoeyp.com.mx
Petsa Express
Tel: 616 596 8801

Correo: gerardo.mendez@grupopetsa.com
Agriceres
Tel: 800 902 3737
Correo: info@agriceres.com
Fb: Agriceres
Ig: agriceres
W: agriceres.com
Nuñez
Tel: (311) 122 5506
Correo: alan.nunez@agronunez.mx
Fb: Implementos Agrícolas Nuñez
INDUMENTARIA
E’boots Western Shop by Evo
Tel: 686 190 7479
Correo: victorariel4@gmail.com
Fb: E’boots
Ig: Ebootsmxli
Estrella Boots
Tel: 616 128 0958
Correo: Estrellaboots.sys@gmail.com
Fb: Estrella boots SyS Ig: Estrellaboots.sys
Kelder W: @kelder.mx
Lilys Showroom
Tel: 646 153 0455
Correo: Ivonne8312@gmail.com
Fb: Lilys showroom Ig: Lilys.showroom
UPE Uniformes Profesionales
Tel: 646 295 2269
Correo: Info@uniformesprofesionales.mx
Fb: Uniformes Profesionales Ig: uniformesprofesionales.mx W: uniformesprofesionales.mx
Sanimex
Tel: 646 149 5260 / 646 149 5261
Bio Sanidad S de RL de CV
Tel: 664 104 4140
Correo: biosanidad@gmail.com W: Dikeninternational.com
Servicios Integrales Agronomicos (SEINA )
Tel: 668 815 0501 / 668 137 4016
Correo: seina_ac@outlook.com y seina_acf@ outlook.com
Fb: Seina AC W: uiseina.com.mx
Baños AD
Tel: 616 108 5850
Correo: sanitarios.ad@gmail.com
Fb: AD Renta de Baños Portátiles
INSUMOS ELECTRICOS
HC Electrificaciones
Tel: 616 166 2433
Correo: corraleshermanos@gmail.com
Fb: Vtas Corrales Hnos
Invernaderos Especializados
Tel: 351 108 3642
Correo: ventas@tunnel-tek.com
Fb: Tunneltek Ig: tunneltekmx
Invertuneles
Tel: 351 145 9720
Fb: Invertuneles
W: invertuneles.com
Polímeros de Ensenada
Tel: 646 177 552
Correo: ventas@polimerosdeensenada.com.mx
Favelab
Tel: 686 360 7017
Correo: mexicali@favelab.com.mx
Fb: favelabmx
Sepa Ecológica
Tel: 686 310 3132
Correo: claudiaperez@sepaecologica.mx
Fb: sepaecologica.mx
Grupo Madlam
Tel: 616 101 5334
Maquinaria Frontera
Tel: 616 166 3889
Correo: marketing@tractoresverdes.com
Fb: Maquinaria Frontera Distribuidor John Deere
Ig: maquinariafrontera
Isemym
Tel: 616 165 4379
Correo: ingmm91@hotmail.com
Fb: ISEMYM CAMALU
Nemaq Agrosoluciones
Tel: 646 173 8730
Fb: nemaq.mx
Ig: nemaq.mx W: nemaq.mx
Empresas MATCO - División Agrícola
Tel: 800 226 2826
Correo: www.matco-masseyferguson.com.mx W: info@matco.com.mx
Jordan Implement De Mexico
Tel: 686 562 0627 / 616 596 2579
Fb: jordanimplementmx W: jordanmexico.mx
Agrícola Automotriz Del Centro IDM
Tel: 616 107 0964
Correo: eric.moreno@agromotriz.com
Monval Industrial
Tel: 664 361 0362
Correo: contacto@monvalind.com
Fb: monvalind.com
Somsi
Tel: 664 884 1038 / 686 170 7196
Correo: alvaro.alarcon@somsi.com.mx
W: somsi.com.mx
Total Water De Mexico
Tel: 686 288 1702 / 686 288 1693
Correo: marketing-diseno@totalwater.com.mx / chacon.m@totalwater.com.mx / atencionaclientes@totalwater.com.mx
Fb: Total Water de Mexico
W: totalwater.com.mx
UET Water / Inodem
Tel: 646 151 3925
Correo: Francisco.palacios@inodem.com.mx W: uetwater.com
Ur Hidroagricola
Tel: 616 113 5309
Correo: administracionsq@ur-hidroagricola. com.mx
Fb: urhidroagricola.com.mx
Rijk Zwaan México
Tel: 667 173 8597
Correo: rzmexico@rijkzwaan.com
Fb: rzmexico
Capgen
Tel: 667 473 8013
Correo: seedscgr@gmail.com
Fb: dir.administrativo@pnm.com.mx
Ingeniería GPS
Tel: 462 181 5085
Correo: pablo.alvarez@ingenieriagpsmexico.com
Fb: ingenieriagpsmx
RH Tech Mexico
Tel: 667 458 1865
Correo: Hector.ruelas@rhtechmexico.com.mxFb: RHtechMexico
Ig: rhtechmexico
W: rhtechmexico.com
TELECOMUNICACIONES
SDN Comunicaciones
Tel: 646 227 0473
Correo: empresarial@satelitedelnorte.com.mx
Fb: SDN Comunicaciones
Kenton Telekom
Tel: 616 165 1403
Correo: hola@kentontelekom.com
Fb: kentonoficial
Monsat “ Monitoreo Satelital”
Tel: 664 674 1539
Correo: director@monsat.com.mx
Fb: Monsat monitoreo gps & eld
Nutrimentos Mexicanos
Tel: 686 561 0031 / 646 182 9867
Correo: victorm@nutrimex.com.mx Ventaszonacosta@nutrimex.com.mx
Fb: Nutrimex
W: Nutrimex.com.mx
Guga Mercantil
Tel: 664 688 0714
Correo: marketing@guga.com.mx
Fb: gugatijuana
Ig: gugatijuana
Poder DIESEL
Tel: 664 287 0217
Correo: poderdieseltijuana@gmail.com
OTROS
Aceros SVM
Tel: 616 118 0699
Correo: svmacerosvazquez@gmail.com
Fb: SVM Aceros San Quintín
AMET-Soluciones Integrales
Tel: 646 385 7273
Correo: joandra.b.terrazas@gmail.com
Fb: AMET-Soluciones Integrales
BC-Tags
Tel: 646 264 8730
Correo: contacto@bc-tags.com
Fb: BC-Tags
Ig: bc.tags
Canacintra San Quintín
Tel: 616 115 2225
Correo: oficinasanquintin@canacintraens.org
Fb: Canacintra San Quintín
Ecomuebles
Tel: 646 596 2311
Correo: Ventas3@ecomuebles.mx
W: Ecomuebles.mx
Escuela Superior de Agricultura Hermanos
Escobar Campus Hermosillo
Tel: 662 105 7499
Correo: esahe.hermosillo@gmail.com
W: esahe.mx
Hospital Medica Zhur
Tel: 616 165 2212
Correo: medica.zhur@hotmail.com
Fb: Medica Zhur
Instituto de Movilidad Sustentable del Estado de Baja California
Correo: Instituto de Movilidad Sustentable del Estado de Baja California
Kuroda
Tel: 646 130 8174
Correo: marco.haro@kuroda.com
Fb: Kuroda
Mayicosportfiching and tours
Tel: 646 170 0396
Correo: mayicogonzalez1@gmail.com
Fb: mayicossportfishing and tours
Ig: mayico gonzalez
Pinturas San Diego
Tel: 646 238 9420
Correo: pinturassandiego@live.com.mx
Fb: Pinturassandiego
Ig: Pinturassandiego
Qualitas Compañía de Seguros
Tel: 616 166 6390 / 616 113 6907
Correo: sanquintin@qualitas.com.mx / sanquintin_administrativo@qualitas.com.mx
Fb: Qualitas Compañía de Seguros San Quintín
Residencial viñedos del mar
Correo: aleeperalta5@gmail.com
Solaire Compresores
Tel: 625-0387
Correo: mercadotecnia@solucionesdeaire.com
Fb: solairecompresores
Verificación Y Certificación Pamfa
Tel: 452 502 0849
Correo: admin.oc@pamfa.mx
Fb: Pamfa AC
Ig: pamfa.ac
W: pamfa.com.mx
Viveros Fall Creek Mexico
Tel: 384 733 8077
Correo: mexico@fallcreeknursery.co
Fb: Fall Creek
W: fallcreeknursery.com

